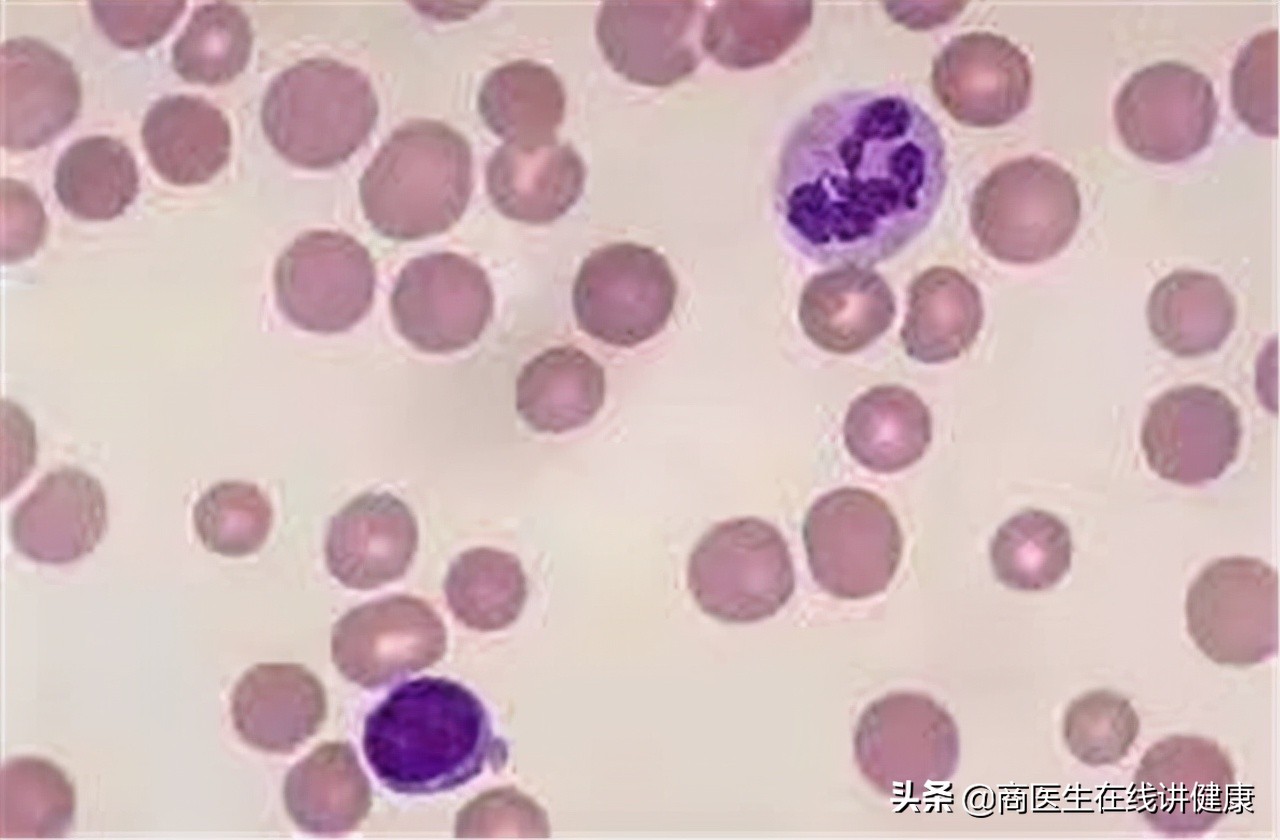
糖尿病人用甲钴胺好还是用b12好,糖尿病神经病变吃甲钴胺还是b12

陈先生,42岁。四个月前意外发生了车祸,小腿胫骨部位受撞击发生二级粉碎性骨折,送入医院抢救,在医院进行了三个月的治疗,小腿骨折部位恢复好后就出院了,回到家后发现自己总是全身无力,偶尔会出现四肢麻木的情况,陈先生以为是自己小腿骨折造成的,但是最近一段时间, 陈先生发现自己的手总是不自觉的震颤,出现眼球不自觉上下摆动的情况, 陈先生决定去医院检查。

通过简单的问诊,了解到陈先生发生车祸时,出现了头部撞击,结合陈先生的主述症状, 疑似是脱髓鞘和视神经脊髓炎, 把陈先生收治在神经内科住院部,进行详细的检查和治疗。
通过头部CT和MRI发现患者头部没有出现病变,但是存在髓鞘受损的情况。
通过脑积液检查发现患者 脑脊液 成分正常 ,没有 感染现象也无髓鞘病变 情况。
通过 神经电生理检查,发现神经传递出现异常,视神经传递异常较明显 。
确诊陈先生为 早期脱髓鞘疾病。

经过多次会诊,与患者沟通确定治疗方案。
陈先生为早期脱髓鞘疾病, 主要以药物治疗为主,采用甲钴胺促进髓鞘恢复, 同时采用对症治疗药物,针对陈先生出现的手抖等症状,我们选择治疗肌肉痉挛的药物,以巴氯芬为主。
待患者病情稳定时选择免疫调节类的药物在缓解期使用。出院后三个月定期复诊。

甲钴胺对于糖尿病患者来说可能非常熟悉,甲钴胺用于治疗糖尿病神经病变有良好的效果,其实甲钴胺的用处不仅只有这些,对于治疗和改善许多疾病都有很好的效果。让我们重新认识一下甲钴胺。
甲钴胺是什么?

甲钴胺是维生素B12的辅酶, 是一种内源性维生素,是维生素B12家族的一份子。甲钴胺在机体内可存在于血液和髓液当中,它对神经元的敏感性很强,通常用于促进神经传导,正是因为这一功能,常被用于改善和治疗糖尿病神经病变。
甲钴胺因其特殊的形态,可以参与脱氧核苷合成,所以甲钴胺有促进轴索和髓鞘再生的作用。因为这一作用甲钴胺也用于改善其他疾病。
甲钴胺有什么作用?

我们最熟悉的作用就是 改善糖尿病神经病变,因为甲钴胺对神经元非常敏感,所以甲钴胺能够刺激神经元起到促进整个神经系统传导的作用。
当糖尿病发生神经系统方面的病变时甲钴胺能够刺激神经系统,达到改善糖尿病神经病变的作用。
甲钴胺在临床上最常用于治疗和预防糖尿病神经并发症,糖尿病发生神经病变时,可能会诱发糖尿病视网膜神经病变或糖尿病足底神经病变,所以甲钴胺在这一方面的作用非常大。

除了改善糖尿病神经病变,甲钴胺还能改善哪些疾病?
除了改善糖尿病神经病变甲钴胺还能改善髓鞘疾病、改善巨幼细胞贫血、改善弥漫性神经疼痛,改善面目神经麻木这四种疾病。

1.改善脱髓鞘疾病 。
上面陈先生发生了 脱髓鞘疾病 ,我们采用 甲钴胺配合其他药物进行治疗 , 脱髓鞘疾病的病理本源是神经细胞受损,而甲钴胺参与核苷合成,有促进髓鞘再生的作用 。
髓鞘是神经细胞的外壳,有促进神经细胞传导的作用,当发生脱髓鞘疾病时,采用甲钴胺,能够很好的 促进髓鞘合成从而有利于神经细胞传导恢复 ,所以促进髓鞘生成,有利于改善脱髓鞘疾病以及其他系统髓鞘炎。我们出现脱髓鞘疾病时,可以考虑用甲钴胺进行改善和治疗。
2.改善巨幼细胞贫血。
甲钴胺是一种能够存在于机体血液中的活性物质,活性物质不需要经过肝脏或肠道的转化,可以直接被吸收利用,所以当我们服用甲钴胺后,它能够快速的进入血液促进红细胞的成熟,加速红细胞生长和代谢。
因为它这一特性所以可以用于治疗或改善巨幼细胞性贫血,效果非常明显。我们出现巨幼细胞贫血时, 可以用甲钴胺增加细胞的生成和代谢,平衡贫血现象。

3.改善弥漫性神经疼痛。
甲钴胺可以用来治疗弥漫性神经炎引起的神经疼痛,常用于治疗神经性皮炎和带状疱疹后遗神经疼痛。我们之所以会发生神经疼痛是由于神经元或神经纤维受损导致的,而甲钴胺能够改善神经元和纤维受损, 在修复神经时,甲钴胺有改善神经疼痛的效果,服用一段时间后效果很明显。
甲钴胺对于骨骼损伤诱发的周围神经疼痛也有不错的效果。出现骨骼损伤诱发的神经疼痛或者是神经炎引起的神经疼痛,皆可用甲钴胺进行治疗和改善。

4.改善面目神经麻痹 。
面目神经麻痹又叫做面瘫,是由于面目神经损伤或面目神经迟钝造成的面无表情症状。面瘫不及时治疗会出现面目抽搐,面目肌肉痉挛的现象,可能出现歪嘴,斜眼等严重情况,所以改善面目神经麻痹非常重要。
我们人体面目神经非常丰富,用于调动表情,面目表情是我们重要的交流方式。 出现面目神经麻痹时需要及时用甲钴胺进行改善,甲钴胺对神经元对神经传导的作用很好,而面目神经麻痹就是神经传导出现了问题,我们促进神经传导就能改善面目神经麻痹的情况,达到治疗和改善的效果。

甲钴胺的作用非常广泛,主要作用是用于神经传导和巨幼红细胞性贫血,在神经传导方面的治疗,不仅是体现内分泌方面的糖尿病神经病变,对于神经内科神经疾病也有不错的效果。甲钴胺的作用非常广泛, 治疗疾病的关键是正确使用药物。
怎样正确使用甲钴胺?
正确使用甲钴胺主要有3点:
避免重复用药,部分人群慎用,在医师的指导下使用。

避免重复用药。 甲钴胺的本质是一种维生素b12的辅酶,维生素b12的辅酶还有很多,我们要避免与此类药物重复使用,以免发生维生素B12毒副作用,除了要避免与维生素b12的辅酶同时使用,还要避免与维生素b12重复使用。
过量的维生素b12人体无法正常吸收和代谢,可能会诱发机体过敏反应,出现呼吸困难,面诊,哮喘等。所以在使用甲钴胺之前,一定要告知医生现在正使用的药物,以免发生重复用药的现象。
部分人群要慎用 。对甲钴胺过敏的人群不能使用,孕妇儿和儿童要慎用。虽然关于甲钴胺是否对孕妇和儿童安全性尚且不明确,但是这类人群在选择药物时一定要谨慎。 老年人因为机体各方面功能下降,所以在使用甲钴胺时要适当减少剂量。

在医师的指导下用药, 这是所有处方药的用药原则。一般情况下,甲钴胺在使用一个月后,对疾病没有效果时就不需要再使用了,但是具体什么时候停药,需要在医生的指导下进行。
对甲钴胺剂量的把控也需要在医生的指导下进行,个人体质不同,神经损伤疾病的程度不同,使用甲钴胺的计量也有出处。
随着病程的发展,医生会适当的增加剂量来推进疾病痊愈,药物增减剂量都需要身体各项指标数据为依据,我们自己无法精准的选择合适的剂量,所以要在医生的指导下用药。
甲钴胺的用法用量

甲钴胺是一种活*药性**物,所以储存方法要避光低温, 在使用甲钴胺时也要注意避光,药片制剂的甲钴胺开封后要立即服用,肌肉注射类的甲钴胺注射时要避免反复注射,以免造成组织神经损伤,注射时应避免神经分布密集的部位,注射甲钴胺或静脉推进甲钴胺出现刺痛情况,立即停止给药。 注射和静脉推进甲钴胺都需要避光,采用避光输液器。

甲钴胺是维生素b12的一种,主 要用于改善糖尿病神经病变。除了这一作用,还能够改善髓鞘疾病、改善巨幼细胞贫血、改善弥漫性神经疼痛,改善面目神经麻木这四种疾病 ,上面提到的陈先生发生了脱髓鞘疾病,医生就是选择甲钴胺来治疗。
我们在使用甲钴胺时要遵循三个原则, 避免重复应用药,部分人群要慎用,在医生的指导下用药 。甲钴胺是活*药性**物,见光易分解,口服用药开启时立即服用,注射和静推需要避光进行。